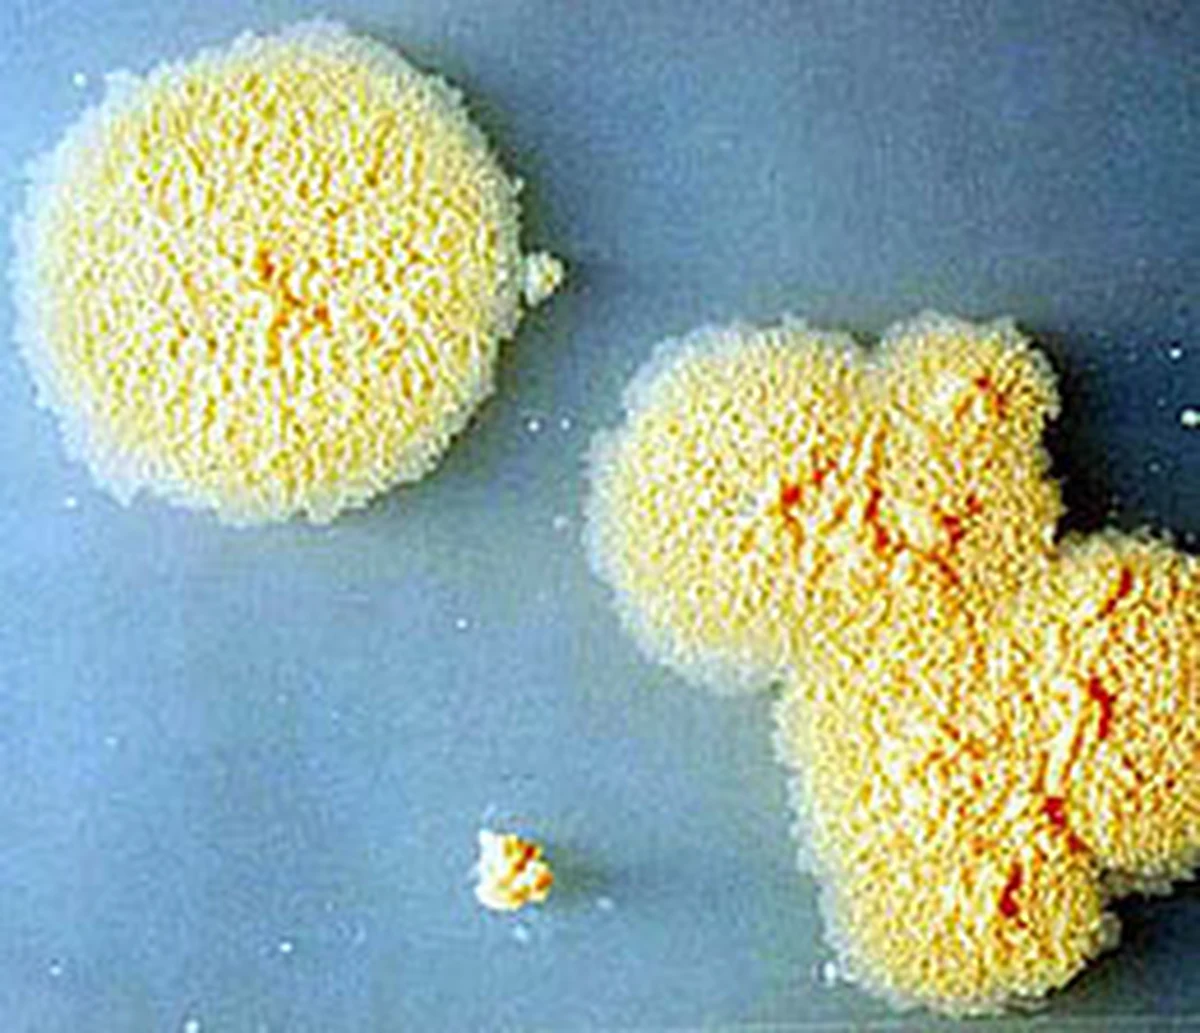
Bakteria, powszechnie występująca w glebie może pomóc nam szybciej się... uczyć - przekonują naukowcy The Sage Colleges w Troy w stanie New York. Ich badania pokazują, że kontakt z Mycobacterium vaccae sprawia, że myszy znacznie szybciej pokonują labirynt. Przed trzema laty wiele rozgłosu zyskały doniesienia o antydepresyjnym działaniu tych bakterii. Wszystko wskazuje na to, że przyczyna obu tych efektów może być ta sama.

Bakteria, powszechnie występująca w glebie może pomóc nam szybciej się... uczyć - przekonują naukowcy The Sage Colleges w Troy w stanie New York. Ich badania pokazują, że kontakt z Mycobacterium vaccae sprawia, że myszy znacznie szybciej pokonują labirynt. Przed trzema laty wiele rozgłosu zyskały doniesienia o antydepresyjnym działaniu tych bakterii. Wszystko wskazuje na to, że przyczyna obu tych efektów może być ta sama.
Wcześniejsze badania pokazywały, że pod wpływem kontaktu z tymi bakteriami w mózgu myszy tworzy się więcej neuronów, które odpowiadają za produkcję serotoniny, hormonu, który łagodzi stany lękowe i redukuje objawy depresji. Ponieważ serotonina ma także wpływ na zdolności uczenia się i zapamiętywania, naukowcy z Troy postanowili sprawdzić, czy korzystny efekt kontaktu z bakterią będzie widoczny u myszy uczących się poruszania w labiryncie.
Wyniki, ogłoszone dziś podczas 110 Zjazdu American Society for Microbiology w San Diego wskazują na to, że Mycobacterium vaccae i tu okazuje się pożyteczna. Myszy karmione pokarmem z dodatkiem tych bakterii potrafiły przejść przez labirynt nawet dwukrotnie szybciej, niż zwykłe, zdradzały przy tym znacznie mniej objawów zdenerwowania. Z czasem, po usunieciu bakterii z diety efekt zanikał, co sugeruje, że poprawa zdolności poznawczych ma charakter tymczasowy. Po wcześniejszych odkryciach naukowcy sugerowali, że obecność Mycobacterium vaccae w glebie może być przyczyną uspokajającego działania, jakie przynosi nam kontakt z naturą. Teraz wygląda na to, że jeśli chcemy żyć spokojnie i mądrze, spacery na łono natury powinniśmy odbywać jak najczęściej.